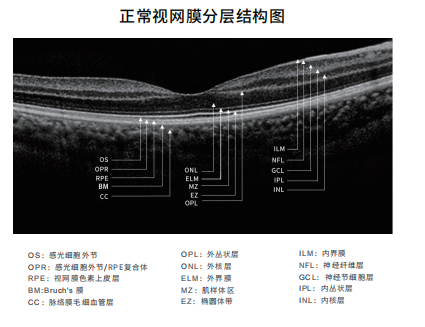
2.png

眼科光学相干断层扫描仪Tai HS 300
商品价格:电议库存情况:现货、预定配送方式:苏州自提或第三方物流订购方式:签约购买咨询热线:18900616086- 产品简介
- 产品参数

眼科光学相干断层扫描仪Tai HS 300
湘械注准20212162072
相干断层扫描仪产品概述
高速:250,000次A-scan/秒行业高速,细节一览无遗。
血管成像:采用目前国内唯获得的知识产权技术,由美蒂迈研发人员与浙江大学科研人员共同研发。
全功能:拥有多种扫描模式,满足不同眼病专科的需求。
高速
拥有目前国内最快的扫描速度,可达250,000次A-scan / 秒,实现快速扫描,速度是同类产品的7.1倍。提高患者配合度,降低图像采集干扰 、提高医生工作效率。
血管成像
OCTA在非接触、无损伤的情况下快速成像,清晰地显示不同层次视网膜及脉络膜血流形态和变化,能快速发现病灶部位,广泛应用于中点性浆液性视网膜病变、脉络膜新生血管、息肉样脉络膜血管病变和糖尿病视网膜病变等多种视网膜 、脉络膜病变中。
避免造影剂带来的副作用,同时为老年人,有严重基础疾病的患者等不适宜行造影检查的人提供了新的选择,具有广阔的临床应用前景。

全功能
Tai HS 300拥有多功能操作,实现眼前节和眼后节的全方面扫描,提供了最广泛的临床应用(屈光/角膜/青光眼/白内障/眼底病专科)。
清晰的角膜成像便于发现各类角膜病变,能自动分析不同区域角膜厚度,能有效地帮助屈光手术的开展。
清晰地显示房角开放情况、视网膜分层,视乳头及神经纤维厚度分析,有助于各类视网膜、脉络膜等疾病的诊断和治疗及青光眼的筛查、评估和诊疗。


